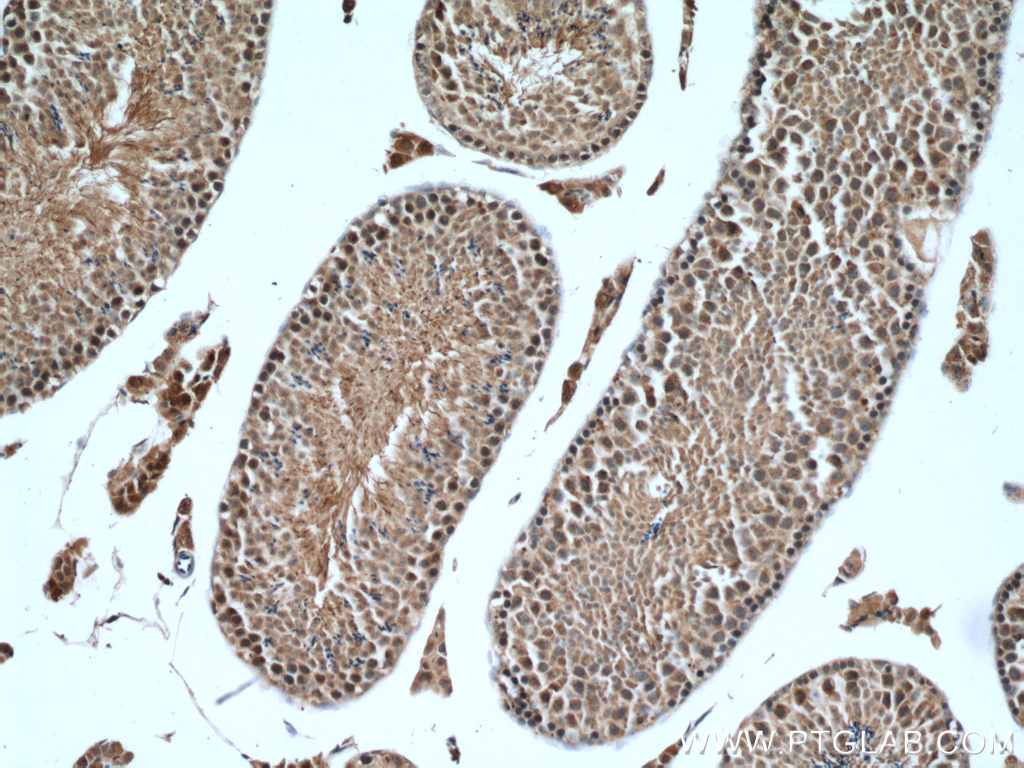

验证数据展示
经过测试的应用
| Positive WB detected in | Raji cells, human kidney tissue, HeLa cells |
| Positive IP detected in | HeLa cells |
| Positive IHC detected in | mouse testis tissue, human heart tissue, human kidney tissue, human placenta tissue, human testis tissue, human skin tissue, human brain tissue, human spleen tissue, human ovary tissue Note: suggested antigen retrieval with TE buffer pH 9.0; (*) Alternatively, antigen retrieval may be performed with citrate buffer pH 6.0 |
推荐稀释比
| 应用 | 推荐稀释比 |
|---|---|
| Western Blot (WB) | WB : 1:500-1:2000 |
| Immunoprecipitation (IP) | IP : 0.5-4.0 ug for 1.0-3.0 mg of total protein lysate |
| Immunohistochemistry (IHC) | IHC : 1:50-1:500 |
| It is recommended that this reagent should be titrated in each testing system to obtain optimal results. | |
| Sample-dependent, Check data in validation data gallery. | |
产品信息
14761-1-AP targets WRAP53 in WB, IHC, IF, IP, ELISA applications and shows reactivity with human, mouse, rat samples.
| 经测试应用 | WB, IHC, IP, ELISA Application Description |
| 文献引用应用 | WB, IHC, IF |
| 经测试反应性 | human, mouse, rat |
| 文献引用反应性 | human, mouse |
| 免疫原 |
CatNo: Ag6522 Product name: Recombinant human WRAP53 protein Source: e coli.-derived, PGEX-4T Tag: GST Domain: 166-548 aa of BC002336 Sequence: TQPENFLKGCKWAPDGSCILTNSADNILRIYNLPPELYHEGEQVEYAEMVPVLRMVEGDTIYDYCWYSLMSSAQPDTSYVASSSRENPIHIWDAFTGELRASFRAYNHLDELTAAHSLCFSPDGSQLFCGFNRTVRVFSTARPGRDCEVRATFAKKQGQSGIISCIAFSPAQPLYACGSYGRSLGLYAWDDGSPLALLGGHQGGITHLCFHPDGNRFFSGARKDAELLCWDLRQSGYPLWSLGREVTTNQRIYFDLDPTGQFLVSGSTSGAVSVWDTDGPGNDGKPEPVLSFLPQKDCTNGVSLHPSLPLLATASGQRVFPEPTESGDEGEELGLPLLSTRHVHLECRLQLWWCGGAPDSSIPDDHQGEKGQGGTEGGVGELI 种属同源性预测 |
| 宿主/亚型 | Rabbit / IgG |
| 抗体类别 | Polyclonal |
| 产品类型 | Antibody |
| 全称 | WD repeat containing, antisense to TP53 |
| 别名 | WDR79, TCAB1, WD repeat-containing protein 79, WD40 repeat-containing protein antisense to TP53 gene, WRAP53beta |
| 计算分子量 | 59 kDa |
| 观测分子量 | 72-75 kDa |
| GenBank蛋白编号 | BC002336 |
| 基因名称 | WRAP53 |
| Gene ID (NCBI) | 55135 |
| RRID | AB_1939806 |
| 偶联类型 | Unconjugated |
| 形式 | Liquid |
| 纯化方式 | Antigen affinity purification |
| UNIPROT ID | Q9BUR4 |
| 储存缓冲液 | PBS with 0.02% sodium azide and 50% glycerol, pH 7.3. |
| 储存条件 | Store at -20°C. Stable for one year after shipment. Aliquoting is unnecessary for -20oC storage. |
背景介绍
WRAP53 (WD40-encoding RNA Antisense to p53), also known as TCAB1 and WDR79, is a multifunctional protein encoded by a gene that produces both a coding mRNA and a regulatory antisense RNA targeting the tumor suppressor p53. Initially identified for its role in maintaining genomic stability by regulating p53 expression, WRAP53 is crucial for telomerase assembly and localization to Cajal bodies, impacting telomere maintenance. It also participates in DNA damage repair and cellular stress responses. The calculated molecular weight of WRAP53 is about 59 kDa, but the actual observed molecular weight is about 72-75 kDa, which may be due to modification.
实验方案
| Product Specific Protocols | |
|---|---|
| IHC protocol for WRAP53 antibody 14761-1-AP | Download protocol |
| IP protocol for WRAP53 antibody 14761-1-AP | Download protocol |
| WB protocol for WRAP53 antibody 14761-1-AP | Download protocol |
| Standard Protocols | |
|---|---|
| Click here to view our Standard Protocols |
发表文章
| Species | Application | Title |
|---|---|---|
Genes Dev The scaffold protein WRAP53β orchestrates the ubiquitin response critical for DNA double-strand break repair. | ||
Nat Chem Biol Observation of processive telomerase catalysis using high-resolution optical tweezers. | ||
Oncogenesis RNF8 ubiquitinates RecQL4 and promotes its dissociation from DNA double strand breaks.
| ||
Aging (Albany NY) Relationship between senescence in macaques and bone marrow mesenchymal stem cells and the molecular mechanism. | ||
RNA Biol Phosphorylation of the Cajal body protein WRAP53β by ATM promotes its involvement in the DNA damage response.
|